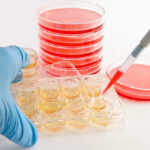

Tissue Microarray Market Insights:
According to the latest tissue microarray market share report predicts the industry size to reach USD 21287.23 Million by the end of the year 2030 with a growth rate of 10.04% CAGR, during the forecast period (2022-2030).
Tissue microarray offers cost-benefit and time efficiency compared to the traditional slide-by-slide tissue analysis. It is likely to accelerate its adoption in the healthcare sector over the next couple of years.
Tissue microarray market benefits from the treatment’s potential to study a wide range of tumors at different phases of disease progression. Tissue microarray has developed an application in diagnosis of cancer through basic research, prognostic oncology, and drug discovery. The rising burden of cancer is one of the major factors favoring the expansion of the tissue microarray market.
Tissue microarray is an efficient tool for identification of new diagnostic and prognostic markers. Its extensive application in drug discovery and research development is one of the major factors projected to drive the tissue microarray market proliferation over the assessment period.
The developments introduced in tissue microarray techniques have simplified the discovery of potential molecular targets for gene-specific therapy which is anticipated to complement the expansion of the market. Nevertheless, its inefficiency for heterogeneous cancer remains an impediment to the market growth.
Market Segmentation:
By procedure, the global tissue microarray market is segmented into immunohistochemistry, fluorescent in-situ hybridization, and frozen tissue array.
By technology, the tissue microarray market has been segmented into DNA microarray, polymerase chain reaction, next-generation sequencing, northern blotting, and western blotting.
By application, the global tissue microarray market is segmented into oncology, gene expression profiling, SNP detection, double-stranded B-DNA microarrays, and comparative genomic hybridization, and sequencing bioinformatics.
By end-user, the tissue microarray market has been segmented into pharmaceutical and biotechnological companies, research organization, and others.
Regional Analysis:
By region, the global tissue microarray market has been segmented into Asia Pacific, Americas, Europe, and the Middle East Africa. Americas is poised to retain a dominant share of the market towards the end of the forecast period. The growth of the region is attributable to the presence of key players, rising healthcare expenditures, adoption of latest technologies in the healthcare sector, and rising burden of cancer among others.
Europe is estimated to control the second largest share of the market. The developed healthcare of the region coupled with government support for research development has augmented the tissue microarray market in the region. The trend is likely to perpetuate in the foreseeable future.
Asia Pacific is expected to grow at a relatively higher CAGR during the projection period. The favorable factors of growth of the regional tissue microarray market size include the presence of fast-developing economies such as India China, increasing healthcare expenditure, developing healthcare sector, government’s initiatives to boost medical tourism, etc.
The Middle East Africa is expected to exhibit sluggish growth. Although the African regions remain laggards, the developments in the healthcare sector of the Middle Eastern countries are set to earn some profits in the forthcoming years.
Competitive Dashboard:
Some of the key players listed in the Tissue Microarray Market trends report are Illumina, Inc., Asterand Bioscience, Pantomics Inc., Applied Microarrays, Arrayit, Phalanx Biotech, Qiagen, Protein Biotechnologies Inc., Takara Bio, Perkin Elmer, Agilent Technologies, Merck Sharp Dohme Corp, and General Electric.
About Market Research Future:
Market Research Future (MRFR) is a global market research company that takes pride in its services, offering a complete and accurate analysis with regard to diverse markets and consumers worldwide. Market Research Future has the distinguished objective of providing the optimal quality research and granular research to clients. Our market research studies by products, services, technologies, applications, end users, and market players for global, regional, and country level market segments, enable our clients to see more, know more, and do more, which help answer your most important questions.
Contact Us:
Market Research Future (Part of Wantstats Research and Media Private Limited)
99 Hudson Street, 5Th Floor
New York, NY 10013
United States of America
+1 628 258 0071 (US)
+44 2035 002 764 (UK)
Email: sales@marketresearchfuture.com
Website: https://www.marketresearchfuture.com